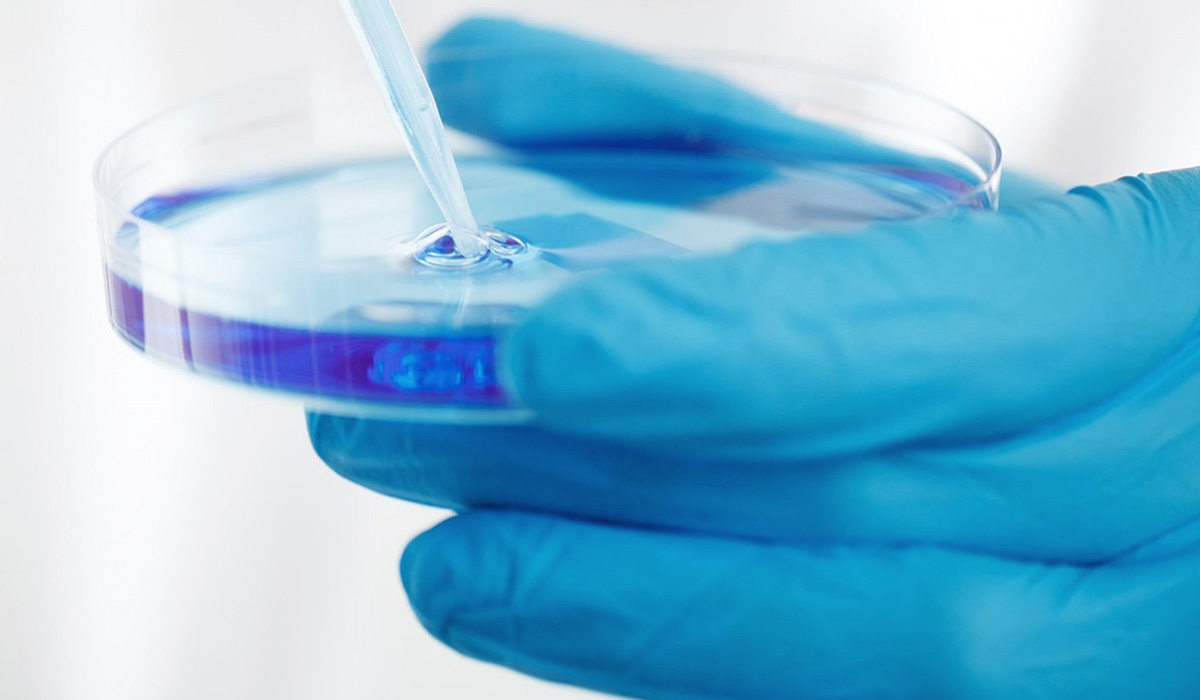
BioCold marketing materials

BioCold: Industrial Marketing Through Strategic Branding
Situation: Creating Brand Identity for Technical Products Manufacturer
BioCold is a manufacturer of controlled temperature and humidity chambers, which can range from reach-in chambers (20-80 cubic feet) to walk-in chambers (50-5,000 square feet). These chambers are used in everything from laboratory research to pharmaceutical manufacturing to many other specialized applications.
Most of the clients that BioCold works with are architects and general contractors who are looking to invest in walk-in controlled temperature and humidity chambers. However, they are currently looking to increase their sales to end users, in addition to those architects and contractors.
The industrial manufacturing market requires brands that communicate professionalism, quality, and expertise. BioCold needed a brand identity that would help them stand out from the crowd, especially for end users who may search online for options.

Task: Create Logo Standing Out in Industrial Market
The problem that BioCold has run into is that these end users they are targeting often don’t know much about various manufacturers. The challenge required:
- Market differentiation: Logo design that helps stand out from crowd
- Professional communication: Brand identity that communicates professional and excellent service
- Quality positioning: Visual identity that positions as manufacturer taking job seriously
- First impression: Brand that creates positive first impression for prospective buyers

Understanding Industrial Marketing
If you are a manufacturer of technical products, then you must know by now that marketing in this industry is vastly different from marketing on a consumer level. Industrial marketing varies from consumer marketing in very big ways. The key differences include:
- Product complexity: The products you’re selling are much more complex than normal consumer products. The difference between marketing a pair of shoes and controlled temperature and humidity chambers is vast.
- Buyer knowledge: The people who are buying your industrial products are much more knowledgeable than normal passive consumers.
- Sales timeline: The marketing process for selling industrial equipment is on a much longer timeline than consumer marketing.
When you take these differences into account, you can see that the marketing process is much more intensive on the industrial side. However, there’s one marketing tool that’s necessary, no matter what kind of marketing you’re doing: a great logo. Your company’s logo is the first impression you give to prospective buyers, giving them an idea of what you’re all about and what sets you apart from the competition.

Action: Strategic Brand Development
Logo Design: Professional Excellence
BioCold didn’t have a logo that would help them stand out and wasn’t sure if they could come up with one on their own. That’s when their team approached our talented branding team to create a logo that would stand out from the crowd.
Our branding team got to work and developed a text/design logo that showed off the professional and excellent service that’s provided by BioCold. The logo is simple, professional, and includes BioCold’s tagline. It’s pretty obvious when you look at this logo that BioCold is a manufacturer that takes their job seriously and wants to ensure that their clients get exactly what they want.
Result: Brand Identity That Stands Out
The brand identity we created for BioCold successfully helps them stand out in the competitive industrial manufacturing market. The comprehensive brand transformation delivers:
Strategic Outcomes
- Market differentiation: Logo design successfully helps stand out from crowd
- Professional communication: Brand identity successfully communicates professional and excellent service
- Quality positioning: Visual identity successfully positions as manufacturer taking job seriously
- First impression: Brand successfully creates positive first impression for prospective buyers
- Complete brand system: Professional logo, brand identity system, and visual language create unified experience
Implementation Success
Today, BioCold uses this comprehensive brand identity to attract clients who need reliable, professional manufacturing services. The professional logo design communicates quality and expertise to both architects and contractors as well as end users who may be searching online for controlled temperature and humidity chamber solutions. The brand successfully ensures BioCold stands out whether clients encounter them through referrals, online searches, or direct inquiries, with logo design that shows off the professional and excellent service that’s provided by BioCold, making it obvious that BioCold is a manufacturer that takes their job seriously and wants to ensure that their clients get exactly what they want.
Brand Name Strategy: Creating “BioCold”
The name “BioCold” was developed through Spellbrand’s strategic brand naming process. Our team researched the competitive landscape, target audience, and brand positioning to create a name that would resonate in the market and support long-term brand growth.
The naming process included linguistic analysis, trademark screening, domain availability verification, and brand storytelling to ensure “BioCold” would be distinctive, memorable, and legally protectable. Learn more about our brand naming service or explore our full naming portfolio.


